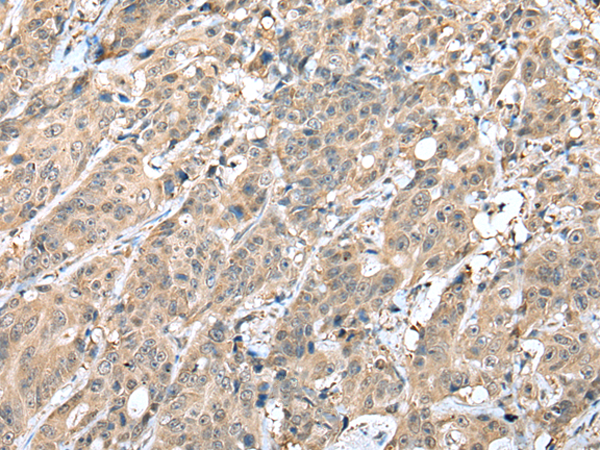
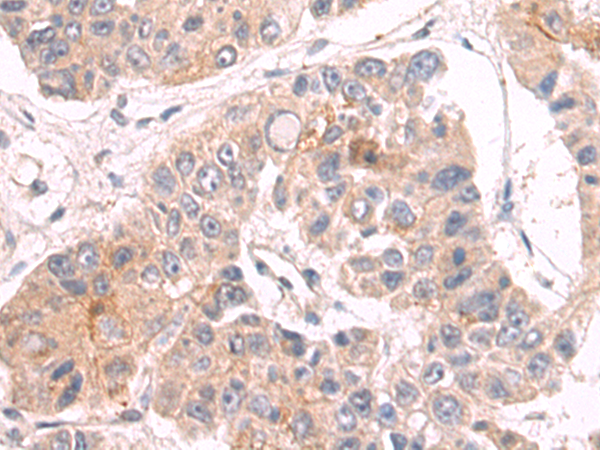
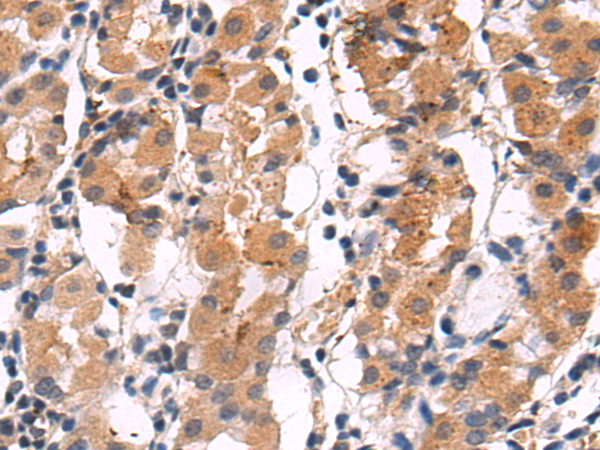

-
分类: 科研抗体货号: P02060别名: ESSS; Np15; P17.3; NP17.3; CI-ESSS; LSDMCA3应用: WB,IHC反应种属: Human, Mouse
-
分类: 科研抗体货号: P02082别名:应用: WB,IHC反应种属: Human, Mouse, Rat
-
分类: 科研抗体货号: P01999别名: VDAC-3; HD-VDAC3应用: WB,IHC反应种属: Human, Mouse, Rat
-
分类: 科研抗体货号: P02050别名: MOK2; HOK-2应用: WB,IHC反应种属: Human, Mouse
-
分类: 科研抗体货号: P02080别名: HIF1; MOP1; PASD8; HIF-1A; bHLHe78; HIF-1alpha; HIF1-ALPHA应用: IHC反应种属: Human, Mouse
-
分类: 科研抗体货号: P01994别名:应用: WB,IHC反应种属: Human
-
分类: 科研抗体货号: P02076别名:应用: WB,IHC反应种属: Human, Mouse, Rat
-
分类: 科研抗体货号: P02044别名: TEX27应用: WB,IHC反应种属: Human, Mouse, Rat
-
分类: 科研抗体货号: P02114别名: METAP1D; MAP 1D; Metap1l; MetAP 1D应用: WB,IHC反应种属: Human, Mouse
-
分类: 科研抗体货号: P02072别名: AF1Q应用: IHC反应种属: Human, Mouse, Rat

鄂公网安备42018502007531号
鄂公网安备42018502007531号

